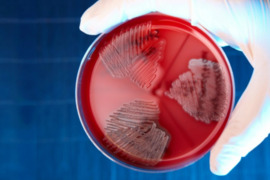
.

Dünyada xəbərlər
KİV: ABŞ və Britaniya Qərb raketlərinin Rusiyanın dərinliklərinə buraxılması qərarını elan etməyəcəklər
Böyük Britaniya və ABŞ yaxın həftələrdə Ukraynaya "Storm Shadow" raketləri ilə Rusiyanın dərinliklərindəki hədəflərə zərbə vurmağa icazə vermək barədə gizli qərar qəbul edə bilərlər. "Report" xəbər verir ki, bu barədə "The Times" qəzeti diplomatik mənbələrə istinadən bildirib
22 sentyabr 2024
Politico: ABŞ İraqdan qoşunların çıxarılması planlarını elan edəcək
ABŞ gələn həftə İraqdan Amerika hərbi kontingentinin çıxarılması planlarını elan etməyi planlaşdırır. "Report" xəbər verir ki, bu barədə "Politico" qəzeti Amerika administrasiyasındakı mənbələrə istinadən məlumat verib. Nəşrə görə, Amerika qoşunlarının çıxarılması planının razılaşdırılmas
22 sentyabr 2024
Zelenski müdafiə nazirini və kəşfiyyat rəhbərini işdən çıxara bilər
Ukraynanın müdafiə naziri Rustem Umerov və Baş Kəşfiyyat İdarəsinin rəhbəri Kirill Budanov tutduqları vəzifələrdən azad oluna bilərlər. xəbər verir ki, bu barədə ctrana.news məlumat yayıb. Qeyd olunur ki, Baş Kəşfiyyat İdarəsinin rəis müavinləri Viktor Zaytsev və İqor Ostapenkonun işdən çıxarılması barəd
22 sentyabr 2024
Rusiya XİN: "Ukrayna ilə bağlı sülh sammitlərində iştirak etməyəcəyik"
Rusiya Xarici İşlər Nazirliyinin sözçüsü Mariya Zaxarova bildirib ki, Moskva Ukrayna ilə bağlı sülh sammitlərində iştirak etmək niyyətində deyil. bu barədə RİA Novosti-yə istinadən xəbər verir. Bununla da, o, Volodimir Zelenskinin noyabrda ikinci sülh sammiti keçirmək və Rusiyanı dəvət etmək niyyət
22 sentyabr 2024
İlanlar məşhur kurort adasını ZƏBT ETDİ
İspaniyanın məşhur kurort adası İbiza at nalı ilanlarının işğalı qarşısında aciz qalıb. xarici KİV-ə istinadən xəbər verir ki, İbiza Araşdırma İnstitutu (IEE) ilanların bütün adanı zəbt etdiyini təsdiqləyib. Onlar invaziv növlərdir, buna görə də yayılması İbizanın biomüxtəlifliyi üçün təhlükə yaradır
22 sentyabr 2024
Budapeştdə 11 il ərzində ən böyük daşqının pik nöqtəsi gözlənilir
Macarıstanın paytaxtı Budapeştdə daşqının pik nöqtəsinin sentyabrın 21-də gözlənildiyi bildirilir. "Report" "Infostart"a istinadən xəbər verir ki, Dunay çayında suyun səviyyəsi təxminən 8,5 metrə qədər qalxacaq ki, bu da normadan beş metr yüksəkdir. Ölkənin Su Təsərrüfatı Baş İdarəsini
22 sentyabr 2024
Fransanın yeni hökumətinin tərkibi təsdiqlənib
Fransa hökumətinin yeni tərkibi bir neçə həftəlik gərgin məsləhətləşmələrdən sonra təsdiq edilib. "Report" xarici KİV-ə istinadən xəbər verir ki, Fransa prezident administrasiyasının rəhbəri Aleksi Koler nazirlərin siyahısını açıqlayıb. "Demokratik Hərəkat Partiyası"ndan olan Jan-Noe
22 sentyabr 2024
Zelenski: "Ukrayna hələ ABŞ və Britaniyadan Rusiya ərazisinə zərbələr üçün icazə almayıb"
Ukrayna Prezidenti Volodimir Zelenski bildirib ki, Ukrayna Rusiya ərazisinin dərinliklərində uzaqmənzilli raketlərdən istifadə etmək üçün hələ ABŞ və Britaniyadan icazə almayıb. xəbər verir ki, bu barədə məlumat yayıb. "Nə ABŞ, nə də Böyük Britaniya bizə bu silahları Rusiya ərazisində, heç bir məsafədək
21 sentyabr 2024
Parisdə yeni hökumətə və Makronun siyasətinə qarşı aksiya keçirilir
Fransa prezidenti Emmanuel Makronun yürütdüyü siyasət və sağ mərkəzçi Respublikaçılar Partiyasının nümayəndəsi Mişel Barnyeni baş nazir təyin etmək qərarı ilə razılaşmayan 1 00-dən çox insan Parisdə Bastiliya meydanı yaxınlığında etiraz nümayişinə çıxıb. Bu barədə "Report" TASS-a istinadə
21 sentyabr 2024
İsrail ordusu Livanda "Hizbullah" hədəflərinə zərbələr endirib
İsrail Hərbi Hava Qüvvələri Livanda "Hizbullah"ın 180-ə yaxın hədəfinə zərbələr endirib. "Report" xəbər verir ki, bu barədə ordunun mətbuat xidməti məlumat yayıb. Hücum zamanı atış qurğuları üçün minlərlə konteyner məhv edilib. Qeyd olunur ki, hücuma məruz qalan raket buraxılış qurğular
21 sentyabr 2024
PKK-nın Avstriya təşkilatlanmasının qadın üzvü İstanbulda saxlanılıb
PKK terror qruplaşmasının Avstriya təşkilatlanmasının üzvlərindən biri olan Çiğdem Aslan İstanbulda saxlanılıb. "Report" xəbər verir ki, bu barədə "Yeni Şafak" məlumat yayıb. Bildirilib ki, o, Milli Kəşfiyyat İdarəsinin keçirdiyi əməliyyat nəticəsində ələ keçirilib. Əməliyyatın detallar
21 sentyabr 2024
Türkiyə ordusu İraqda yeni əməliyyat keçirib, 17 terrorçu öldürülüb
Türkiyə Silahlı Qüvvələri İraqın şimalında yeni əməliyyat keçirib. "Report" xəbər verir ki, bu barədə Türkiyənin Milli Müdafiə Nazirliyindən bildirilib. Qeyd olunub ki, Qara, Hakurk və Qəndildə keçirilən əməliyyat nəticəsində 17 terrorçu öldürülüb
21 sentyabr 2024
Teleaparıcıdan etiraf: "İsrail İranda əməliyyat keçirib və SEPAH zabitləri öldürülüblər"
İranın "Əsr" telekanalının "Meydan" verilişinin aparıcısı Vəhid Xəzzab bildirib ki, ötən ay İsrail qüvvələri İran ərazisində gizli əməliyyat keçirib, bir sıra sənədləri oğurlayıb, bəzi mərkəzlərdə təxribat törədib və iki SEPAH zabitini öldürüblər. Bu barədə "Azad İran" "Telegram"
21 sentyabr 2024
ABŞ Məxfi Xidməti Trampa sui-qəsd cəhdi zamanı öz uğursuzluğunu etiraf edib
ABŞ Məxfi Xidmətinin əməkdaşları iyulda ölkənin keçmiş prezidenti Donald Trampa sui-qəsd zamanı yol verdikləri səhvlərə görə cəzalandırılıblar. bu barədə RBK-ya istinadən xəbər verir. "Bu, Amerika Birləşmiş Ştatlarının Məxfi Xidməti tərəfindən uğursuzluq idi. 13 iyul uğursuzluqlarına görə məsuliyyət
21 sentyabr 2024
Martinik hakimiyyəti şiddətli etirazlardan sonra nümayişləri qadağan edib
Karib dənizində yerləşən Fransaya məxsus Martinik adasında hakimiyyəti həyat dəyərinin artmasına qarşı şiddətli etirazların bu həftənin əvvəlində komendant saatının tətbiqinə səbəb olmasından sonra dörd bələdiyyədə nümayişləri qadağan edib. bu barədə "Reuters"ə istinadən xəbər verir. Məlumat
21 sentyabr 2024
İsrailin Beyruta endirdiyi aviazərbələr nəticəsində ölənlərin sayı 19-a çatıb
İsrail Hərbi Hava Qüvvələrinin Livanın paytaxtı Beyrutun cənub ətrafına endirdiyi aviazərbələr nəticəsində ölənlərin sayı 19-a yüksəlib, 66 nəfər yaralanıb. "Report" AP-yə istinadən xəbər verir ki, bu barədə Livanın Səhiyyə Nazirliyinin icmalında deyilir. Təxminən 20 nəfər itkin düşüb. Yerl
21 sentyabr 2024
Honkonqda infeksiya partlayışı: Streptokokka yoluxanların sayı kəskin artıb
Honkonqda insanlar üçün ölümcül olan B qrupu streptokokların (Streptococcus agalactiae) səbəb olduğu infeksiya partlayışı nəticəsində yoluxanların sayı 70-ə çatıb. -ın şəhərin Səhiyyə Departamentinin nəzdindəki Sağlamlığın Qorunması Mərkəzinə istinadən verdiyi məlumata görə, üç xəstə vəfat edib. Be
21 sentyabr 2024
ABŞ Alyaskaya əlavə qüvvələr göndərir
ABŞ hakimiyyəti Alyaskaya əlavə qüvvələr göndərir, çünki Rusiya və Çinin regionda daha aktiv fəaliyyət göstərdiyini düşünür. bu barədə TASS-a istinadən xəbər verir. Məlumata görə, ABŞ silahlı qüvvələri Alyaska yaxınlığında tədricən mövcudluğunu artırır, Rusiya və Çinin hərbi fəaliyyətinin artması səbəbində
21 sentyabr 2024
13 ildən sonra ilk dəfə məhkumu iynə vurub öldürdülər
ABŞ-ın Cənubi Karolina ştatında 13 ildən sonra ilk dəfə məhbus edam edilib. xarici mediaya istinadla bildirir ki, qətldə təqsirli bilinən Freddi Evqene Ouens öldürücü inyeksiya ilə (öldürücü iynə vurularaq) edam edilib. Eyni zamanda ştatın qubernatoru Henri Makmaster Ouensin əfv tələbini rədd edib. Məlumat
21 sentyabr 2024
Harris yeni debat raundunun keçirilməsinə nail olmağa çalışır
ABŞ vitse-prezidenti, demokratlardan ali dövlət vəzifəsinə namizəd Kamala Harris əsas siyasi rəqibi - respublikaçı Donald Trampla yeni debat raundunun keçirilməsinə nail olmağa çalışır. bu barədə TASS-a istinadən xəbər verir. "Mən daha bir debat keçirməyə çalışıram. Görək nə olacaq", - dey
21 sentyabr 2024
Zelenski Trampla nə vaxt görüşəcəyini açıqladı
Ukrayna Prezidenti Volodimir Zelenski ABŞ prezidentliyinə namizəd Donald Trampla sentyabrın 26-27-də görüşəcək. "Qafqazinfo" "RBK-Ukraina"ya istinadən xəbər verir ki, bu barədə jurnalistlərə açıqlamasında V.Zelenski danışıb. Onun sözlərinə görə, gələn həftə ABŞ-yə səfəri zamanı prezidentliy
21 sentyabr 2024
Həqiqət üzə çıxdı: Əmisi ilə anasını birgə görən Narin…
Avqustun 21-i Quran kursundan çıxdıqdan sonra itkin düşən və 19 gün sonra cəsədi tapılan Narin Güran cinayəti ilə bağlı etirafçı Nevzat Bəxtiyar həqiqətləri açıqlayıb. -a istinadən bildirir ki, bu barədə Türkiyə mətbuatı məlumat yayıb. Bildirilib ki, ciddi təhlükəsizlik nəzarəti altında ədliyyəyə gətirilə
21 sentyabr 2024
20 il əvvəl edilən tatu qaraciyər sirrozuna səbəb oldu
20 il əvvəl edilən tatu Uelsdən olan bir kişidə qaraciyər sirrozuna səbəb olub. Qaynarinfo-ya istinadən xəbər verir ki, Uels sakini Endryu Edi özünü pis hiss edib və döş qəfəsinin infeksiyası şübhəsi ilə həkimə müraciət edib. Həkim xəstənin mədəsinin böyük ölçüdə böyüdüyündən narahat olduğunu bildiri
21 sentyabr 2024
Ərdoğanın vəzifəsini müvəqqəti olaraq icra edəcək şəxsin adı açıqlandı
Türkiyədə Prezident Rəcəb Tayyib Ərdoğanın vəzifəsini müvəqqəti olaraq vitse-prezident Cevdet Yılmaz icra edəcək. bu barədə "Resmi Gazete"yə istinadən xəbər verir. Məlumata görə, buna səbəb Rəcəb Tayyib Ərdoğanın ABŞ-yə səfəridir. Qeyd olunub ki, prezidentin sentyabrın 21-dən 26-dək davam edə
21 sentyabr 2024
İngiltərədən vətəndaşlarına çağırış: O ölkəni tərk edin!
Böyük Britaniyanın xarici işlər naziri Devid Lammi Livanın baş naziri Necip Mikati ilə telefon danışığı aparıb. Ölkə.Az xarici KİV-ə istinadla xəbər verir ki, bu barədə Lammi sosial şəbəkə hesabından məlumat yayıb. "Mikati ilə danışdım və Livanda artan gərginlik və mülki əhalinin itkiləri ilə bağl
20 sentyabr 2024
Geyindiyi köynəyə görə 14 aylıq həbs olundu - FOTO
Çində 27 yaşlı gənc geyindiyi qısaqol köynəyə görə, 1 il 2 ay müddətinə azadlıqdan məhrum edilib. Ölkə.Az xarici KİV-ə istinadla xəbər verir ki, buna səbəb onun geyiminin üzərində yazılan sözlər olub. Hadisə Çinin Honq Konq Xüsusi İnzibati Bölgəsində baş verib. Belə ki, Çu Kay-ponq adlı şəxs iyunda metr
20 sentyabr 2024
Kadırov İlon Maskdan gileyləndi: "Kişiliyə yaraşan hərəkət etmir"
Amerikalı sahibkar İlon Mask Çeçenistan rəhbəri Ramzan Kadırova hədiyyə olunan "Cybertruck"ı sıradan çıxarıb. -a istinadən xəbər verir ki, bu barədə Kadırov öz "Telegram" kanalında bildirib. Onun sözlərinə görə, maşın manevr qabiliyyəti və ekipajın yaxşı müdafiəsi ilə döyüş meydanınd
20 sentyabr 2024
"X"in bu ölkədəki qadağası götürüldü
Amerikalı milyarder İlon Mask "X" sosial media platformasının serverlərə daxil olma üsulunu dəyişdirib. Ölkə.az -a istinadən xəbər verir ki, "X"in 20 milyondan çox aktiv istifadəçisi var. Buna baxmayaraq, Braziliyada olan mübahisələr səbəbilə avqustun sonundan etibarən sosial şəbək
20 sentyabr 2024
Yerə asteroid yaxınlaşır
Sentyabr ayının sonunda 2024 PT5 asteroidi Yerə yaxınlaşaraq 56 gün müddətində onun müvəqqəti ikinci peykinə çevriləcək. Bu barədə Ölkə.az-a Nəsirəddin Tusi adına Şamaxı Astrofizika Rəsədxanasından məlumat verilib. Bildirilib ki, 2024 PT5 asteroidi avqustun 7-də Madriddə Komplutens Universitetinin astronomlar
20 sentyabr 2024
Putin Meksikaya getməmək qərarı verdi - Həbs ediləcəkdi?
Rusiya prezdenti Vladimir Putin Meksikanın yeni seçilmiş prezidenti Klaudiya Şeynbaumun andiçmə mərasimi üçün Roma Statutunu imzalamış Meksikaya getməyəcək. Qaynarinfo xəbər verir ki, bu barədə Rusiya Xarici İşlər Nazirliyinin Latın Amerikası Departamentinin direktoru Aleksandr Şetinin RTVI-yə müsahibəsind
20 sentyabr 2024
Həftəsonu məktəblərdə dərs olmayacaq - Rəsmi açıqlama
Prezidentin ad günündən ailə - Fotosu
Planetin ən hündür 10 heykəli - Yerləşdiyi yer və ölçüləri...
Ruslan Eyyubovun sahildəki 15 hektarlıq bağ evi - Burada gizli liman var?
Almaniya 100 gün tam izolyasiyada yaşayacaq könüllülər axtarır - 23 min avro ödəniləcək
98 yaşlı Ömər Eldarov ad günündə belə rəqs etdi - Video
Prezidentin ayaq saxladığı pilləkənlərdə nə yazılıb? - Video
Yeni İldə neçə gün iş olmayacaq? - Nazirlər Kabinetindən açıqlama
Bakının 10 qəsəbəsində yaşayanlara VACİB XƏBƏR
Üçüncü övladı dünyaya gəlib
Növbəti iki gündə hava şəraiti qeyri-sabit olacaq (XƏBƏRDARLIQ)
Bakıda marşrut avtobusu ağır qəzaya düşdü - 2 ölü, 9 yaralı - Video - Yenilənib
Oqtay Əsədovun qızı vəfat etdi
"Toya az adam dəvət etdim, cəmi 300 nəfər" - Əlikram Bayramov
"Balaca Heydərin iki oğlu var" - Prezident - Video
